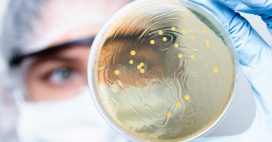
Ne confondez pas virus et bactérie ! Ne confondez pas virus et bactérie !

Pleine lune : les hommes sont plus sensibles aux troubles du sommeil que les femmes
Les femmes et les hommes sont sensibles à la lune et à la lumière qu’elle émet mais pas autant.

Selon une étude réalisée par une équipe de chercheurs suédoise, la lune aurait bien des effets sur le sommeil, notamment chez les hommes. Ils seraient plus sensibles à sa lumière que les femmes.
Des troubles du sommeil liés à la lune
Fascinante et mystérieuse, la Lune continue de nous livrer ses secrets. Bien que cela ne soit pas prouvé scientifiquement, l’astre de la nuit est souvent tenu pour responsable de nos sautes d’humeur qui nous rendent si « lunatiques ». Elle est aussi connue pour avoir une influence sur les cycles menstruels féminins qui se synchroniseraient sur la lune. Selon une équipe de chercheurs suédoise, elle aurait également des effets chez les hommes.
Réalisée entre 2001 et 2018, auprès de 492 femmes et 360 hommes âgés de 22 à 81 ans, une étude a mesuré l’impact des cycles de la lune sur le sommeil. Pour ce faire, les scientifiques ont utilisé un polysomnographe, un appareil qui permet de détecter les troubles du sommeil. Ils ont étudié les nuits des participants lorsque la lune était en phase montante et en phase décroissante, c’est-à-dire, du premier jour de la pleine lune à celui de la suivante.
Les hommes sont plus sensibles que les femmes
Les résultats obtenus, ont permis à Christian Benedict, professeur à l’Université d’Uppsala et principal auteur de l’étude, d’affirmer « que les hommes dont le sommeil a été enregistré pendant les nuits de la période de croissance du cycle lunaire présentaient une efficacité de sommeil plus faible et un temps d’éveil plus long après le début du sommeil par rapport aux hommes dont le sommeil a été mesuré pendant les nuits de la période de décroissance. En revanche, le sommeil des femmes est resté largement insensible au cycle lunaire, » lit-on dans Medisite.
Face à la lune et à ses effets, il existe donc des disparités entre les hommes et les femmes. Celle-ci serait liée à une sensibilité plus élevée des hommes à la lumière ambiante. Au final, durant la période montante de la lune, les hommes perdent en moyenne vingt minutes de sommeil et les femmes douze minutes. Huit minutes d’écart qui font toute la différence.
Lire aussi
A lire absolument